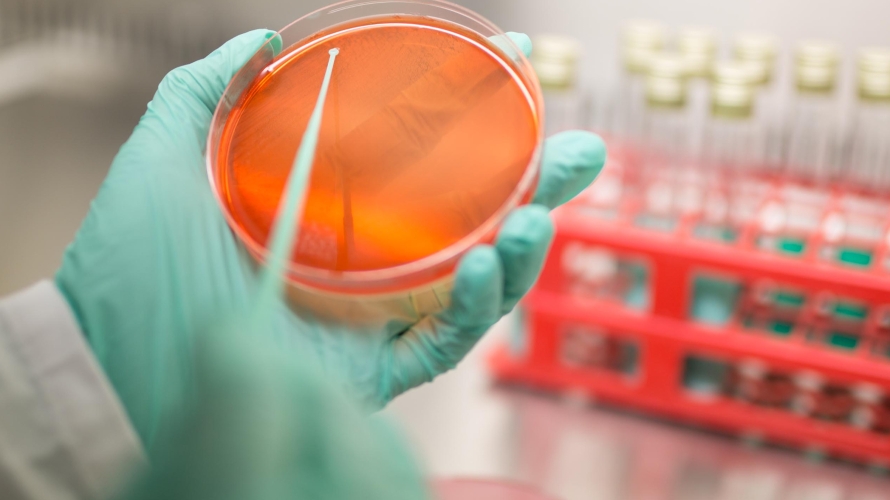
s

Inginer industrie alimentară în laborator
Alătură-te echipei noastre!
Ne dorim să alcătuim o echipă unită în cadrul laboratorului nostru de analize din Bocșa, Caraș-Severin.
În această echipă căutăm un inginer industrie alimentară/medic veterinar care să efectueze analize microbiologice.
Cerințe:
- Studii superioare de specialitate, cunoştinţe despre protocoale de analize fizico-chimice;
- Experiență în cadrul unui laborator.
Dacă ești interesat/ă, vino și aplică pe site-ul nostru la secțiunea ”Lucrează cu noi” sau aplică printr-un cv la email sau ne găsești la telefon la 0755.050.202/0258.814.466.
De asemenea poți depune un CV la adresa str. Binișului, nr. 10, loc. Bocșa, Jud. Caraș-Severin.
Join our team!